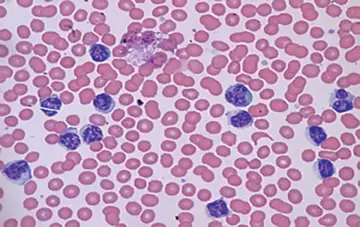

شماره ۱۱۲۶
هماتولوژی - صفحه 6
شماره ۱۱۲۵
شماره ۱۱۲۵
شماره ۱۱۲۴
شماره ۱۱۲۲
شماره ۱۱۲۱
شماره ۱۱۲۱
شماره ۱۱۲۰
شماره ۱۱۱۹
شماره ۱۱۱۷
شماره ۱۱۱۶